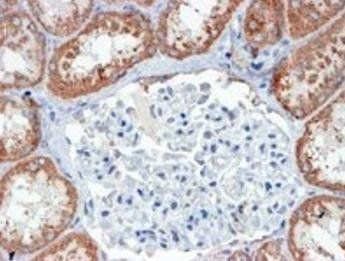
USP16/UBP-M Antibody

You have no items in your shopping cart.
Cart summary

Anti-USP16 Antibody
Catalog Number: orb2611360
Product Properties
| Catalog Number | orb2611360 |
|---|---|
| Category | Antibodies |
| Description | Anti-USP16 Antibody. Tested in ELISA, Flow Cytometry, IF, IHC, ICC, WB applications. This antibody reacts with Human, Monkey, Rat. |
| Clonality | Polyclonal |
| Species/Host | Rabbit |
| Isotype | Rabbit IgG |
| Conjugation | iFluor647 |
| Reactivity | Human, Monkey, Rat |
| Form/Appearance | Lyophilized |
| Concentration | Adding 0.2 ml of distilled water will yield a concentration of 500 μg/ml. |
| Purification | Immunogen affinity purified. |
| Immunogen | E.coli-derived human USP16 recombinant protein (Position: K9-L823). |
| UniProt ID | Q9Y5T5 |
| MW | 100 kDa |
| Tested applications | ELISA, FC, ICC, IF, IHC, WB |
| Application notes | Western blot, 0.25-0.5μg/ml, Human, Monkey Immunohistochemistry (Paraffin-embedded Section), 0.5-1μg/ml, Human, Rat Immunocytochemistry/Immunofluorescence, 2μg/ml, Human Flow Cytometry (Fixed), 1-3μg/1x106 cells, Human ELISA, 0.1-0.5μg/ml, -. Add 0.2ml of distilled water will yield a concentration of 500ug/ml |
| Cross Reactivity | No cross-reactivity with other proteins. |
| Antibody Type | Primary Antibody |
| Storage | Store at -20°C for one year from date of receipt. After reconstitution, at 4°C for one month. It can also be aliquotted and stored frozen at -20°C for six months. Avoid repeated freeze-thaw cycles. |
| Alternative names | Ubiquitin carboxyl-terminal hydrolase 16; Deubiqui Read more... |
| Note | For research use only |
Images
Similar Products
USP16 Antibody [orb654381]
ELISA, FC, ICC, IF, IHC, WB
Human, Monkey, Rat
Rabbit
Polyclonal
Unconjugated
100 μgUsp21 Rabbit Polyclonal Antibody [orb330751]
WB
Bovine, Canine, Equine, Guinea pig, Human, Rabbit, Rat
Mouse
Rabbit
Polyclonal
Unconjugated
100 μlUSP16/UBP-M Antibody [orb18534]
ELISA, IHC
Bovine, Canine, Mouse, Porcine, Rat
Human
Goat
Polyclonal
Unconjugated
100 μg
Reviews
Anti-USP16 Antibody (orb2611360)
Based on 0 reviews
Participating in our Biorbyt product reviews program enables you to support fellow scientists by sharing your firsthand experience with our products.
Login to Submit a Review